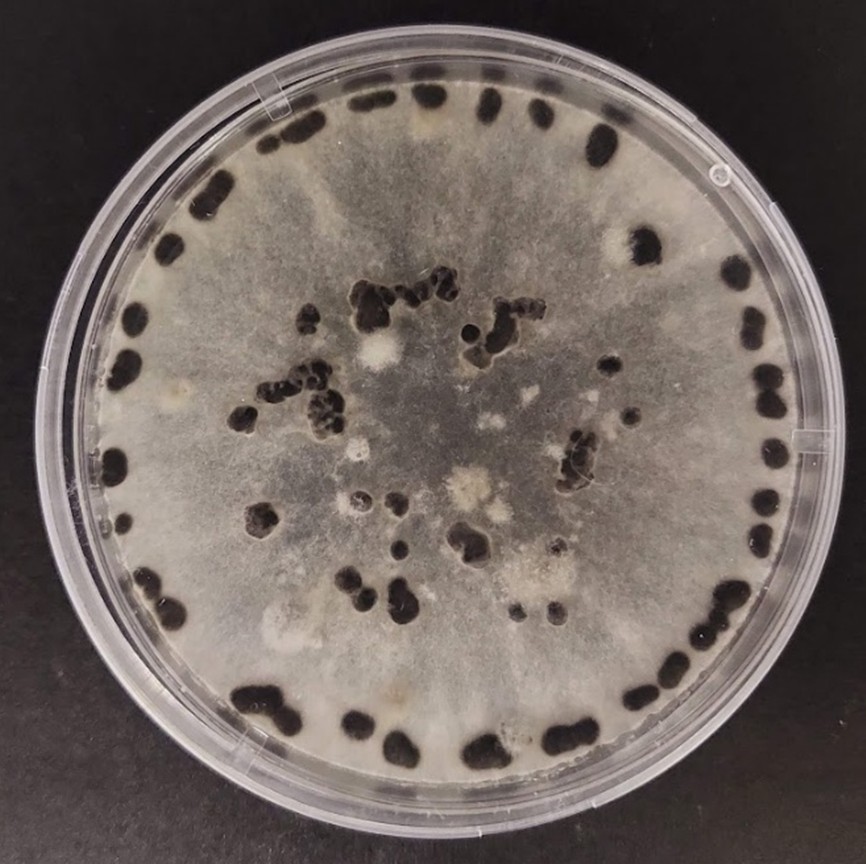

Alida van Dijk
@alidavandijk4
Plant path, mycology, and CRISPR nerd 🌱🧬| PhD candidate at @Fabiteam1 🔬 | Lover of all things fungi 🍄 | She/her 🏳️🌈 Opinions are my own.
ID: 1380215919146831872
08-04-2021 17:48:28
588 Tweet
4,4K Followers
3,3K Following


Prof. Brett Hurley Brett Hurley, professor at the University of Pretoria, giving his talk on global perspectives on biocontrol agents in plantation forests at the annual #TPCP2025 meeting. 🌲 #TreeHealth CROPWATCH AFRICA


Dr Sam van Holsbeeck Sam Van Holsbeeck, from the University of the Sunshine Coast, sharing his insights into solutions for priority plant pest and pathogen management in Australian forestry plantations. 🌲 #TPCP2025 #TreeHealth #Forestry


"Forest pests and pathogens know no boundaries.” Prof. Irene Barnes Barnes & Prof. Mike Wingfield share lessons from the RGE-FABI Tree Health Programme: collaboration is key, monitoring is vital, and sharing tools & tech accelerates impact. #TPCP2025 #TreeHealth #FABI


I've been part of the diagnostic clinic for 4 years, and it's incredible to see how it's grown. Dr. Wilma Nel, PhD shared how this work - field visits, lab processing, and diagnostics - helps detect current and emerging pests & diseases. Proud to be part of it! #TPCP2025 #TreeHealth



Prof. Emma Steenkamp presents on SIGS (spray-induced gene silencing) for managing Fusarium circinatum in nurseries - exploring innovative, targeted strategies to protect young pines from this devastating pathogen. #TPCP2025 #Fusarium #TreeHealth #SIGS #FABI




A thought-provoking panel discussion wraps up #TPCP2025 Day 2: exploring the complexities of building sustainable, effective partnerships between government, industry, and academia to protect forest health. FABI ICFR Forestry SA Global Change Institute National Dept. of Land Reform & Rural Development


Forest pathology molecular model system Oostlander et al. A. Oostlander Bernard Slippers @fabiteam1 📖 nph.onlinelibrary.wiley.com/doi/10.1111/np…





Advancing forest pathology: the need for community‐driven molecular experimental model systems - Oostlander, Fleißner & Slippers - New Phytologist - Wiley Online Library nph.onlinelibrary.wiley.com/doi/full/10.11… Anne Oostlander FABI UP Faculty of Natural and Agricultural Sciences @uptuks TU Braunschweig

Silent invaders: The hidden threat of asymptomatic phytobiomes to forest biosecurity Tanney, Kemler, Vivas, Wingfield, Slippers New Phytologist - Wiley Online Library nph.onlinelibrary.wiley.com/doi/10.1111/np… FABI UP Faculty of Natural and Agricultural Sciences New Phytologist